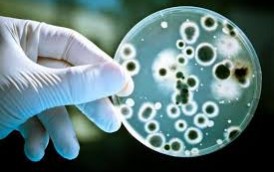

ԱԺԲ անդամ, դիվանագետ Արա Պապյանի գրառումը. «Եթե ՀԱՊԿ-ի եզրափակիչ հռչակագիրը չստորագրելուց հետո ՀՀ-ն դեռ շարունակի մնալ ՀԱՊԿ-ում (որն այդպես էլ լինելու է), ուրեմն՝ այս ամենը բեմականացում էր՝ ՀԱՊԿ-ի հայ-ադրբեջանական հակամարտությանը չմիջամտելու համար արդարացում ու հիմքեր գտնելու համար։ Եթե մինչ նոյեմբերի 23-ի հանդիպումը ՀԱՊԿ-ն ինչ-որ չափով փորձում էր պատրվակներ գտնել իր պարտավորությունները չկատարելու համար, հիմա ասելու է՝ մենք պատրաստ էինք, ՀՀ չստորագրեց։ Ի դեպ, ինչո՞ւ հարց չի բարձրացվում ՌԴ կողմից 1997թ․ պայմանագրի նորացված տարբերակի հիման վրա ՀՀ հանդեպ պարտավորույթունները չկատարելու մասին»։
«Ինչո՞ւ հարց չի բարձրացվում ՌԴ կողմից ՀՀ հանդեպ պարտավորույթունները չկատարելու մասին»․ Արա Պապյան